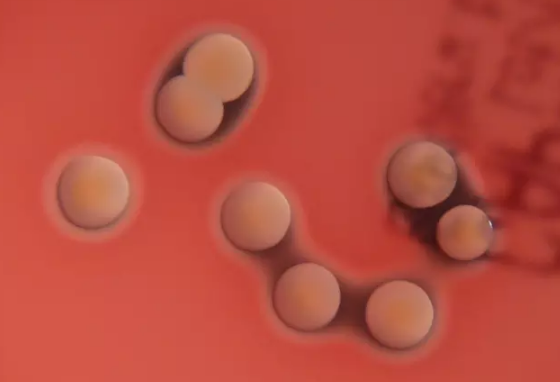

快科技7月3日消息,据媒体报道,厦门10岁男孩浩浩(化名)在海边散步时,不慎在礁石上磕破了右脚后跟。疼痛轻微,未见明显出血,孩子和家长都未在意。
然而,几天后,浩浩右大腿根部突然出现剧烈疼痛,且反复高烧不退,虽经抗生素治疗,病情仍急转直下,已因血压下降出现休克征兆,生命垂危。医疗团队火速将其转入重症监护室(PICU)抢救,并通过病原学检测锁定了这场危机的元凶——金黄色葡萄球菌。
所幸,经医护人员全力救治,浩浩最终脱离生命危险并康复出院。
据了解,金黄色葡萄球菌,隶属于葡萄球菌属,是革兰氏阳性菌代表,以其独特的葡萄状排列形态而得名,广泛潜藏于自然界的各个角落,包括空气、人体表面如皮肤、鼻腔、咽喉乃至肠道内。
其强大的致病能力源自其能够产生多样化的毒素、酶及抗原蛋白,不仅能够引发皮肤软组织、血流、呼吸道等局部感染,也可引起肺炎、伪膜性肠炎、心包炎等,甚至败血症、脓毒症等全身感染。
如何预防金黄色葡萄球菌感染
1、防止金黄色葡萄球菌污染食品
防止带菌人员接触食品;患局部化脓感染的禽、畜尸体应除去病变部位,经高温或其他适当方式处理后进行加工生 产。
2、防止金黄色葡萄球菌肠毒素的生成
应在低温和通风良好的条件下贮藏食物,以防肠毒素形成;在气温高的春夏季,食物置冷藏或通风阴凉地方也不应超过6小时,并且食用前要彻底加热。
3、杀死金黄色葡萄球菌
金黄色葡萄球菌对热和干燥的抵抗力较一般无芽胞细菌强,加热80℃30分钟才被杀死。
【本文结束】如需转载请务必注明出处:快科技
责任编辑:鹿角
新浪科技公众号
“掌”握科技鲜闻 (微信搜索techsina或扫描左侧二维码关注)










